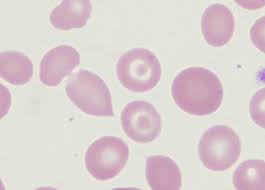

MCV、MCH、MCHCの計算式
MCV(Mean Corpuscular Volume)平均赤血球容積
赤血球1個当たりの、平均的な大きさ
基準値:85~102fL
計算式:{Ht(%)/RBC(×10^4/μL)}×1000 fL(femto liter)
MCH(Mean Corpuscular Hemoglobin)平均赤血球ヘモグロビン量
赤血球1個当たりの、平均ヘモグロビン量
基準値:28~34pg
計算式:{Hb(g/dL)/RBC(×10^4/μL)}×1000 pg
MCHC(Mean Corpuscular Hemoglobin Consentration)平均赤血球ヘモグロビン濃度
赤血球1個当たりの、平均ヘモグロビン濃度
基準値:30.2~35.1%
計算式:{Hb(g/dL)/Ht(%)}×100%
小球性貧血(MCV<80 fL)の鑑別疾患
⓵ 鉄欠乏性貧血(iron deficiency anemia:IDA)
② 慢性疾患に伴う貧血(anemia of chronic disease:ACD)
→「正球性貧血」の項へ
・膠原病、悪性腫瘍、感染症などの慢性疾患による貧血
・除外診断
・正球性貧血だが、経過が長いと小球性になる
→「正球性貧血」の項へ
③ サラセミア
・特定のグロビン鎖の遺伝的な合成障害(常染色体優性遺伝)
・骨髄での破壊(無効造血)や脾臓での破壊(血管外溶血)を反映し、網赤血球増加、標的赤血球の出現を認める
・血管外溶血を反映し、軽度の黄疸や脾腫を認める
・貧血の程度は軽いが、MCVが極端に低い(60fL台が多い)
・小球性赤血球症
・赤血球数、ヘモグロビン値は正常~軽度低下、増加と様々。
・Mentzer index:MCV(fl) / RBC(×10 ⁶ / μL)≦13の場合、サラセミアが強く疑われる
・血清鉄、TIBC、フェリチンは正常~高値(鉄欠乏性との鑑別)
コメント